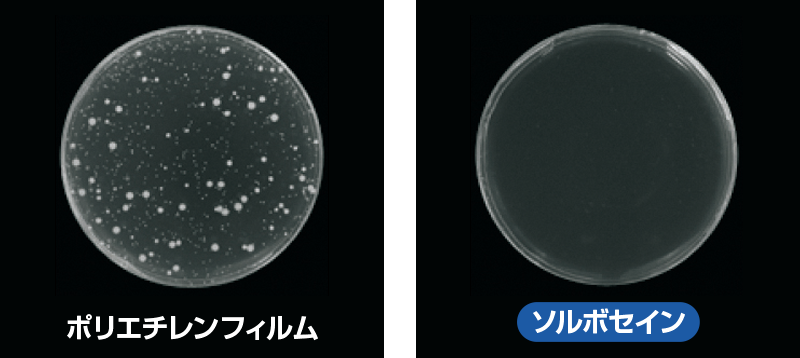
圧力分散と衝撃吸収に優れた人工筋肉素材「ソルボセイン」

装着ラクラク&快適フィット! 腰・ひざ・足を支えるおすすめサポーター3選
~お悩み別サポーター特集~腰・ひざ・足の関節に不安を感じている方へ向けて、JAF通販紀行のトップバイヤーが自信を持ってセレクトしたのは、長時間装着しても心地よく過ごせるサポーターです。人の筋肉の特長を再現した人工筋肉素材「ソルボセイン」を採用し、体への負担をやさしく軽減。動きやすさと快適な装着感を両立しています。「今のサポーターに満足できない」という方や、「ワンランク上の品質を求めたい」という方にぜひおすすめしたいアイテムです。
『〈ソルボ〉楽らく腰ガード』
『〈ソルボ〉楽らくひざガード(同サイズ2枚組)』
『〈ソルボ〉外反母趾サポーター 固定薄型メッシュタイプ(同サイズ2枚組)』
関節の不安や不快感……腰・ひざ・足に起こりやすいトラブルとは?

「腰に違和感がある」「ぎっくり腰がつらい」といった経験をしたことがある方も少なくないでしょう。腰の痛みや張りは、実は約85%がレントゲン検査をしても原因が特定できない“非特異的腰痛”とされています。長時間同じ姿勢で過ごすことや重い物を持ち上げることなど、日常のちょっとした動作が原因で、誰にでも起こり得るのです。
さらに、加齢に伴って現れやすいひざや足のトラブルも大きな悩みの一つです。ひざ軟骨がすり減ると関節の動きがスムーズでなくなり、炎症や痛みにつながるおそれがあります。足では横アーチが崩れることでタコやウオノメができやすくなり、やがて外反母趾の原因になることもあるでしょう。
圧力分散と衝撃吸収に優れた人工筋肉素材「ソルボセイン」
人工筋肉「ソルボセイン」は、人の筋肉のように衝撃エネルギーを吸収し、すぐに元の状態へ戻ろうとする特長を持つ素材です。特に、圧力を分散する性能と衝撃を和らげる力に優れており、体にかかる負担をやさしくサポートしてくれます。普段の生活はもちろん、長時間の装着でも快適さを保ち、体の動きをしっかり支えてくれる心強い存在です。

一般的な発泡ウレタン(スポンジ)は、地面からの圧力が一点に集中してしまい、つぶれてへたりやすいのが難点です。一方、「ソルボセイン」は圧力をバランスよく分散するため、へたりにくく、違和感や不快感の少ない自然な装着感で、体のラインにしなやかに馴染み、快適な状態を保ちます。

上のグラフは、体重60kgの人が厚さ7mmのソルボセインをかかとに装着し、高さ30cmから飛び降りたときの衝撃を測定したものです。装着しない場合と比べると、足にかかる負担を約1/3まで軽減することが確認されています。(メーカー調べ)
この優れた特長を活かし、医療の現場では足の痛みを和らげるインソールやサポーターに、介護の現場では体を動かすことが難しい方の負担を減らすマットやクッションなどに活用されています。
菌の繁殖を抑える衛生的な素材
多様な現場で使用される「ソルボセイン」は抗菌性にも優れ、バクテリアなどの菌の増殖を抑えます。(一般財団法人カケンテストセンター調べ)
次に、「ソルボセイン」を使用したサポーターをお悩みの関節別に詳しくご紹介します。
【腰】安定感あるホールド力で、長時間しっかりサポート

三進興産株式会社の「〈ソルボ〉楽らく腰ガード」は、優れたサポート力で長時間の装着でも快適に過ごせる腰用サポーターです。腰を支える“ボーン”の内側に備えられた人工筋肉素材「ソルボセイン」が圧力を分散し、衝撃を吸収することで肌あたりがやさしく、心地よいフィット感で腰への負担を軽減します。
さらに、腰椎や骨盤を程よく固定し、しゃがんでもお腹がきつくなりすぎず、ゆるくなりすぎない絶妙な安定感で動きをサポートします。使用感だけでなく着け心地の良さにもこだわり、薄手設計でアウターに響きにくく、かさばらず蒸れにくいので、日常使いに重宝します。
●カラー:ブラック、ホワイト
●適応ウエスト周り(約):S=58~78cm/M=68~88cm/L=78~98cm/2L=88~108cm
『〈ソルボ〉楽らく腰ガード』 5,830円(税込)
【ひざ】頼れるサポート力で、慢性的な悩みに寄り添う

「〈ソルボ〉楽らくひざガード(同サイズ2枚組)」は、人工筋肉素材「ソルボセイン」を採用した膝パッドが上部から下部までひざ全体を包み込み、安定感を高めます。床や地面にひざをついても、衝撃や圧力をしっかり吸収・分散し、負担を軽減します。
さらに、サイドサポートが横ゆれやねじれを抑え、パワーベルト編み構造が筋肉やじん帯をしっかり支えます。ひざ裏にはひざを曲げたときの圧迫感を少なくするメッシュ編みを施し、長時間でも快適に着用できます。
●カラー:ベージュ
●適応膝皿上部(約):S=38~42cm/M=42~46cm/L=46~50cm
※立った状態でひざのお皿の10cm上部を計測します。
『〈ソルボ〉楽らくひざガード(同サイズ2枚組)』 6,820円(税込)
【足】専門家監修の構造で、外反母趾を優しく保護

外反母趾研究家・笠原巌氏が監修した「〈ソルボ〉外反母趾サポーター 固定薄型メッシュタイプ(同サイズ2枚組)」は、優れた圧力分散・衝撃吸収素材を採用したソルボ中足パッドが親指の突起部や足裏のタコ・ウオノメを優しく保護し、長時間でも快適な履き心地を実現します。
それに加えて、足甲部分の面ファスナーで中足関節を左右から適度な強さで締めて、しっかりと固定し、ソルボ足指間パッド(母趾用)が補助的に指を自然に広げることで、足裏アーチをサポート。足指を使ってしっかり踏ん張れる歩行へ導きます。締め具合は自由に調整できるので、自分に合ったフィット感で安心して使えます。
●カラー:シルバーグレー
●適応足サイズ(約):S=21.5~23.0cm/M=23.5~25.0cm/L=25.5~27.0cm
※足幅の特に広い方は、1つ大きめのサイズをお選びください
通気性に優れた、薄型&軽量の生地を採用!

サポーターの上から靴下を履いてもOK。パワーメッシュ生地を採用し、縦にも横にも伸びるソフトな質感で、蒸れにくく高い通気性を確保しています。さらに手洗いできるので、清潔さを保てます。
『〈ソルボ〉外反母趾サポーター 固定薄型メッシュタイプ(同サイズ2枚組)』 5,060円(税込)
Editor’s Note
ソルボのサポーターは初心者でも装着しやすく、サイズ調整も本当に簡単です。それに正しい姿勢を自然にキープしてくれるので、体に余計な力を入れずに、座る・立つといった動作をよりスムーズに行いやすくなります。お悩みの関節に合わせたサポーターを取り入れれば、日常生活をより楽に過ごせると思います。
※商品のお届け送料は、JAF通販紀行が負担いたします。
※品切れの可能性および価格が変更になる場合があります。詳細はJAF通販紀行ページでご確認ください。
バイヤー 自慢のイチオシ!の記事一覧

もう失敗しない!お鍋いらずで簡単・便利に作れる理想のゆでたまご
2026.02.27
ドライブ中の飲み物を快適温度に。温も冷もずっと、飲み頃キープ
2026.01.05
足裏全体で着地する独自設計のシューズ! 足やひざにも優しく、スムーズな歩行をしっかりサポート
2025.09.01
首にかけて簡単クールダウン! 超速2秒で冷え、ひんやりが長時間持続する
2025.06.30
「もしも」のときにすぐ持ち出せて安心! 防災時に活躍するクッション型寝袋
2025.03.01
水で薄めてスプレーして拭き取るだけ! 洗車&ワックスが手軽に完了
2024.11.28
予期せぬ事態にこれ1本! 車からの脱出や初期消火に役立つ
2024.09.01











